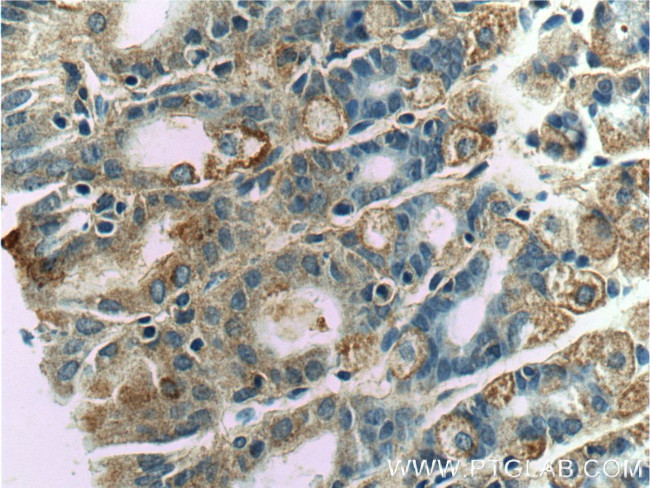
WTX Antibody in Immunohistochemistry (Paraffin) (IHC (P))

Search
Proteintech
WTX Polyclonal Antibody
{{$productOrderCtrl.translations['antibody.pdp.commerceCard.promotion.promotions']}}
{{$productOrderCtrl.translations['antibody.pdp.commerceCard.promotion.viewpromo']}}
{{$productOrderCtrl.translations['antibody.pdp.commerceCard.promotion.promocode']}}: {{promo.promoCode}} {{promo.promoTitle}} {{promo.promoDescription}}. {{$productOrderCtrl.translations['antibody.pdp.commerceCard.promotion.learnmore']}}
产品信息
55432-1-AP
种属反应
宿主/亚型
分类
类型
抗原
偶联物
形式
浓度
规格
纯化类型
保存液
内含物
保存条件
运输条件
靶标信息
The AMER1 gene encodes the protein APC membrane recruitment 1, also known as Wilms tumor 1-associating protein (WT1-associating protein). This protein plays a significant role in the Wnt signaling pathway, which is critical for cellular processes such as proliferation, differentiation, and migration. AMER1 interacts with the adenomatous polyposis coli (APC) protein and is involved in the regulation of β-catenin, a key mediator of Wnt signaling. By recruiting APC to the cell membrane, AMER1 facilitates the degradation of β-catenin, thereby acting as a negative regulator of the pathway. This function is vital in maintaining cellular homeostasis and preventing uncontrolled cell growth. Mutations or dysregulation of AMER1 are associated with various cancers, including colorectal cancer, as aberrant Wnt signaling can lead to oncogenesis. Moreover, germline mutations in AMER1 are linked to conditions such as osteoporosis-pseudoglioma syndrome, highlighting its role in bone development and eye health. Ongoing research focuses on elucidating the detailed mechanisms of AMER1's involvement in signaling pathways and its potential as a therapeutic target in cancer and genetic disorders.
仅用于科研。不用于诊断过程。未经明确授权不得转售。
篇参考文献 (0)
生物信息学
蛋白别名: adenomatous polyposis coli membrane recruitment 1; Amer1; APC membrane recruitment protein 1; family with sequence similarity 123, member B; family with sequence similarity 123B; Protein FAM123B; RP11-403E24.2; unnamed protein product; Wilms tumor gene on the X chromosome protein; Wilms tumor on the X
基因别名: 2810002O09Rik; AMER1; AW492303; FAM123B; OSCS; WTX
UniProt ID: (Human) Q5JTC6, (Mouse) Q7TS75
Entrez Gene ID: (Human) 139285, (Mouse) 72345